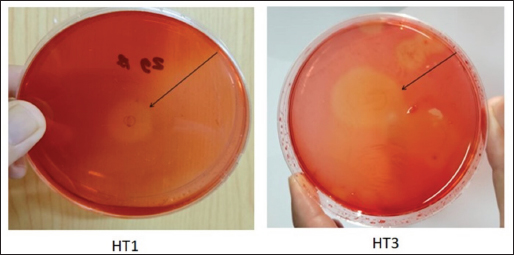
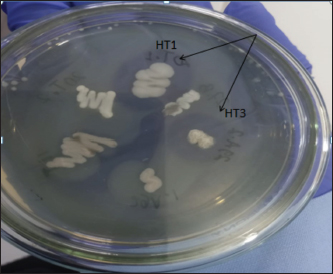

| Research Article | ||
Open Vet. J.. 2025; 15(3): 1358-1369 Open Veterinary Journal, (2025), Vol. 15(3): 1358-1369 Research Article A novel bacterial approach to cassava waste fermentation: Reducing cyanide toxicity and improving quality to ensure livestock feed safetyHera Dwi Triani1,3, Ahadiyah Yuniza1*, Yetti Marlida1, Husmaini Husmaini1, Wulansih Dwi Astuti2 and Gusri Yanti31Departement of Feed and Nutrition, Faculty of Animal Husbandry, Andalas University, Padang, Indonesia 2Research Center for Applied Zoology, National Research and Innovation Agency (BRIN), Bogor, Indonesia 3Faculty of Science, Social and Education, Prima Nusantara Bukittinggi University, Bukittinggi, Indonesia *Corresponding Author: Ahadiyah Yuniza. Department of Feed and Nutrition, Faculty of Animal Husbandry, Andalas University, Padang, Indonesia. Email: yuniza [at] ansci.unand.ac.id Submitted: 22/12/2024 Accepted: 18/02/2025 Published: 31/03/2025 © 2025 Open Veterinary Journal
AbstractBackground: Indonesia has a high production of cassava, and cassava waste has significant potential as an alternative feed. However, the high levels of hydrogen cyanide (HCN) and crude fiber in cassava waste pose safety risks for its use as animal feed. Aim: This study aimed to identify the morphology and molecular characteristics of cyanolytic and cellulolytic bacteria from cassava waste and evaluate their potential in reducing cyanide levels and improving its nutritional value to ensure feed safety. Methods: The first step of this research involved the isolation and screening of cyanolytic and cellulolytic bacteria from cassava waste using DNA sequence homology analysis and constructing a phylogenetic tree. The second step evaluated the potential of the identified bacteria to improve cassava waste as a safe feed. The bacteria were used as inoculants in cassava waste fermentation, employing a factorial, completely randomized design with two factors: types of inoculants and fermentation duration. Data were analyzed using analysis of variance followed by Duncan’s Multiple Range Test. Results: This study identified two novel bacterial strains, namely Proteus vulgaris HT3, and Citrobacter freundii HT1. The application of these bacteria as inoculants in cassava waste fermentation at different durations significantly reduced cyanide content, crude fiber, and pH, while significantly increasing protein content. This improved the quality of cassava feed as a safe feed. Conclusion: Cassava waste fermented for 15 days with C. freundii HT1 produced the best feed quality and safety, with the lowest HCN and crude fiber and high crude protein content. Keywords: Cassava waste, Citrobacter freundii HT1, Cyanide reduction, feed safety, Proteus vulgaris HT3. IntroductionIndonesia is a country with abundant cassava waste, which is attributed to numerous cassava-based food processing businesses. Cassava is a locally sourced product in several regions of the country. These industries generate significant amounts of cassava peels and leaf residues, which hold potential as local feed ingredients. The use of locally available feed resources derived from community waste offers an alternative to providing affordable and sustainable feed solutions. Cassava production in Indonesia accounts for 14,978,310 tons annually (CADIS, 2024), with cassava peels accounting for approximately 5%–15% of the total production. In addition to cassava peels, cassava leaves exhibit significant potential as an alternative feed due to their high protein content (Gundersen et al., 2022). Cassava leaves can yield approximately 10 tons per hectare, with the crude protein content ranging from 33.8% to 37.4% (Enoch et al., 2022). However, a major limitation of using cassava peels and leaves as feed is their anti-nutrient content, particularly cyanide (HCN). Cyanide disrupts cellular respiration by binding to the cytochrome oxidase enzyme, preventing tissue oxygen utilization, resulting in livestock mortality (Suharti et al., 2021). The cyanide content in cassava leaves ranges from 200 to 300 ppm (Anjani et al., 2021), and in cassava peels, it can reach up to 250 ppm (Srisaikham et al., 2018). This is far above the safety limit for feed, which is set at 50 ppm to ensure the health and productivity of livestock (Srisaikham et al., 2018). Feed containing cyanide levels exceeding this limit can compromise safety and pose risks to livestock, making the reduction of cyanide content essential when using cassava waste as feed ingredients. Furthermore, cassava peels have a high crude fiber content (16.25%) and low crude protein content (4.33%), whereas cassava leaves contain approximately 20% crude fiber (Enoch et al., 2022). These factors, along with cyanide content, hinder the direct use of cassava waste as a safe and nutritionally adequate feed resource. Several conventional methods, such as drying, heating, and boiling, have been used to reduce cyanide levels in cassava peels and leaves. However, these methods often result in significant losses of nutrients, particularly proteins. Fermentation is considered a more effective processing method for reducing HCN and crude fiber content while simultaneously increasing protein content. However, conventional fermentation methods can result in up to 58% protein loss (Hawashi et al., 2019). The fermentation process has a significant potential in enhancing the nutritional quality of cassava waste by reducing HCN and crude fiber content. Additionally, fermentation improves the taste and bioavailability of feed ingredients (Marlida et al., 2023) and reduces anti-nutritional factors (Wea et al., 2020). Previous studies have demonstrated that fermentation using cellulolytic microbes is effective in reducing crude fiber but less effective in reducing cyanide (Olurontolo, 2018). On the other hand, fermentation using cyanide-degrading bacteria such as Leuconostoc mesenteroides reduced cyanide content by up to 90.43% in cassava peels and 86.89% in cassava leaves, but only reduced crude fiber content by 2.35% (Triani et al., 2024). Fermentation of cassava peels with Saccharomyces cerevisiae successfully reduced crude fiber and increased crude protein but was less effective in reducing HCN. Meanwhile, fermentation using Bacillus amyloliquefaciens increased crude protein content by 45.34% and reduced crude fiber content by 13.48% (Triani et al., 2024). The effectiveness of fermentation is largely dependent on the microbial strains used. Microbes isolated from cassava waste effectively reduce the anti-nutrient factors present in cassava. Previous studies have identified several bacteria in cassava waste that produce cellulase and β-glucosidase enzymes, which have the potential to serve as inoculants for fermentation to improve the nutritional quality of cassava waste as feed ingredients (Nwakoby et al., 2021; Triani et al., 2024). However, the identification of these bacterial strains has not yet been conducted, and their ability to enhance the quality of cassava waste as feed has not been comprehensively evaluated. Therefore, this study aimed to identify the morphology and molecular characteristics of bacteria isolated from cassava waste and evaluate their ability to enhance the nutritional quality of cassava peels and leaves. The goal is to ensure that cyanide content is reduced to safe levels (below 50 ppm) and that cassava waste can serve as both safe and potential feed ingredient for livestock. Materials and MethodsResearch designThe first stage of this research involved the isolation and morphological as well as molecular identification of cellulolytic and cyanolytic bacteria from cassava waste. Molecular identification was performed through DNA sequence homology analysis and phylogenetic tree construction. This was followed by an evaluation of the bacteria’s ability to improve cassava waste as a feed. The bacteria were used as inoculants in the fermentation of cassava waste, employing a factorial, completely randomized design to determine the optimal bacterial strains and fermentation duration for enhancing feed quality. Identification of cellulolytic and cyanolytic bacteriaBacterial identification was conducted by inoculating bacteria into selective cellulose media (carboxymethyl cellulose [CMC]) and selective cyanide media (potassium cyanide [KCN]). Clear zones around the paper disks indicate cellulolytic activity. Similarly, clear zones on selective cyanide media indicate cyanolytic activity. The bacteria that produced clear zones on both selective media were then subjected to morphological and molecular analysis. Morphological characteristics of cellulolytic and cyanolytic bacteriaMorphological characteristics were determined by macroscopic and microscopic examinations. Macroscopic identification was performed to observe colony characteristics, including shape and margin. Microscopic identification was conducted by examining isolates under a microscope, with a focus on Gram staining and bacterial shape. Molecular identificationMolecular identification involves DNA isolation, amplification of DNA via PCR, analysis of PCR results, DNA sequencing, and phylogenetic analysis (Pazla et al 2024; Abdul et al 2024). Evaluation of bacteria for improving feed quality and safetyThe materials used in this study were cassava peels, and leaves obtained from local cassava chip industries. The inoculants were bacteria HT1 and HT3, which were grown on rice bran medium. The fermentation composition ratio was 80% cassava peel and 20% cassava leaves, with an inoculant dose of 3%. The research employed a factorial, completely randomized design (3 × 3) with four replications. Factor A was the fermentation duration (5, 10, and 15 days), and Factor B was the type of isolate (HT1, HT3, and the combination of HT1+HT3). The parameters observed included crude fiber, cyanide content, crude protein, and pH. Cyanide content was measured using the APAH method (APAH, 2021), crude fiber and crude protein were analyzed using the AOAC method (AOAC, 2021), and pH was measured using a pH meter (Astuti et al., 2013). The best-quality fermented cassava waste was selected for further analysis, including amino acid profiling and complete nutrient content evaluation. Data analysisBacterial identification was a qualitative study, and the results are presented in tables and figures. The evaluation of bacteria for improving feed quality was quantitative. Data were analyzed using analysis of variance to determine treatment effects, followed by Duncan’s multiple range test (Steel and Torrie, 1993) if significant effects were observed. Ethical approvalEthical approval was not required because this study did not include any live animals. ResultsIn the screening of bacteria from cassava waste, two bacterial isolates, HT1 and HT3, were found to produce clear zones on selective media containing CMC and KCN, as shown in Figures 1 and 2. These findings indicate that HT1 and HT3 are cellulolytic and cyanolytic bacteria capable of degrading cellulose and cyanide. Morphological identification revealed that HT1 and HT3 form white, round, and mucoid colonies, respectively, and are aerobic bacteria (Table 1). In the Gram staining test, both isolates were classified as Gram-negative (-), characterized by a pink coloration (Fig. 3). The electrophoresis results indicated that PCR successfully amplified the 16S rRNA gene region of both isolates (HT1 and HT3), as indicated by the formation of bands corresponding to PCR fragments with amplicons of 1498 bp (Fig. 4). Based on BLAST analysis of the 16S rRNA sequence, isolate HT1 showed the highest similarity to Citrobacter freundii strain S519 (Table 3), whereas isolate HT3 was closely related to Proteus vulgaris strain VBE35 (Table 4). In the phylogenetic tree, isolates HA1 and HA2 are located outside the branch chain, suggesting that the HT1 and HT3 isolates represent novel bacterial strains (Figs. 5 and 6).
Fig. 1. Clear zones of isolates in selective cellulose (CMC) media. The results of the study showed that the type of inoculant and fermentation duration had a highly significant effect on the crude fiber content, HCN levels, crude protein content, and pH value (Table 5). The application of these bacteria as inoculants demonstrated that a fermentation duration of 15 days significantly (p < 0.01) reduced crude fiber compared with fermentation durations of 5 and 10 days. However, no significant differences (p > 0.05) were observed between the 5-day and 10-day fermentation durations in terms of crude fiber reduction. The HCN content was significantly lower (p < 0.01) in cassava waste fermented with C. freundii HT1 for 15 days, P. vulgaris HT3 for 5 days, and with the combination of inoculants for 5 and 10 days. Analysis of variance and Duncan’s multiple range test revealed higher crude protein content (p < 0.05) was observed in cassava waste fermented with P. vulgaris strain HT3 for 5–10 days, with mixed inoculants (C. freundii HT1 + P. vulgaris HT3) for 10–15 days, and with C. freundii HT1 for 15 days. Conversely, cassava waste fermented with C. freundii HT1 for 5 and 10 days exhibited significantly higher pH values (p < 0.01) compared with fermentation durations of 15 days.
Fig. 2. Clear zones of isolates in selective cyanide (KCN) media. Table 1. Macroscopic identification of isolates.
Fig. 3. Microscopic analysis of HT1 and HT3. isolates
Fig. 4. Amplification of 16S rRNA gene of isolate. Table 2. Microscopic identification of isolates.
Table 3. BLAST results against NCBI database of HT1 isolate.
Table 4. BLAST results against the NCBI HT3 isolate database.
DiscussionScreening of cellulolytic and cyanolytic bacteriaThe clear zone formed on CMC media indicates the hydrolytic activity of the cellulase enzymes secreted by the bacterial isolates. The hydrolysis products, in the form of glucose, cannot form complex bonds with Congo red (Ejaz et al., 2021). The clear zone observed on KCN media suggests that the isolates are capable of degrading cyanide. Cyanide-degrading bacteria utilize cyanide and its derivatives as a nitrogen source for their growth. These bacteria contribute significantly to bioremediation processes by reducing the cyanide content in the material. Cyanide-degrading bacteria possess specific metabolic pathways for cyanide degradation and mechanisms to mitigate cyanide toxicity (Roldan et al., 2021).
Fig. 5. Phylogenetic tree of HT1 isolate.
Fig. 6. Phylogenetic tree of HT3 isolates Morphological characteristics of cellulolytic and cyanolytic bacteriaIn the oxidase test, both isolates (HT1 and HT3) were oxidase-negative, indicating that they did not produce oxidase. In contrast, in the catalase test, isolates HT1 and HT3 tested negative and positive, respectively, as indicated by bubble formation upon the addition of hydrogen peroxide (H2O2). The catalase test determines whether bacterial isolates produce the enzyme catalase, which hydrolyzes hydrogen peroxide into water and oxygen. Catalase-positive results are characterized by the presence of bubbles after the addition of H2O2 (Roldan et al., 2021). In the motility test, both isolates obtained from cassava waste (HT1 and HT3) exhibited motility. Motile bacteria typically possess flagella that enable their movement (Ardiansyah et al., 2018). The microscopic observations of HT1 and HT3 are summarized in Table 2 and Figure 3. The results revealed that isolate HT1 is a long rod-shaped bacterium, whereas isolate HT3 is a shorter rod-shaped bacterium. In the Gram staining test, both isolates were classified as Gram-negative (-) bacteria, as indicated by the pink coloration. This characteristic results from bacteria possessing a thin peptidoglycan layer in their cell walls. Gram-negative bacteria have a cell wall structure composed of a thin peptidoglycan layer and high lipid content. Isolates HT1 and HT3 were identified as non-spore-forming bacteria because no clear areas indicative of spores were observed in the bacterial cells. This suggests that the isolates studied are not heat-resistant. Spore-forming bacteria can survive and protect themselves under extreme conditions such as heat, cold, and chemical exposure, as well as from parasitic bacteria. In contrast, spore-forming bacilli exhibit relatively high resistance to physical and chemical treatments (Cho and Myong 2020). Gene amplification and 16S rRNA sequence analysisThe electrophoresis results demonstrated that PCR amplified the 16S rRNA gene region of both isolates (HT1 and HT3). This was confirmed by the appearance of PCR products using the primers 27F (AGAGTTTGATCCTGGCTCAG) and 1492R (GTTTACCTTACGACT). The PCR bands exhibited a sufficiently high DNA concentration, allowing for clear visualization under a UV transilluminator Figure 4. These bands corresponded to PCR fragments, producing amplicons of 1498 bp (Fig. 4). The molecular approach aimed to analyze the phylogenetic relationships of the isolates by comparing ribosomal RNA sequences using 16S rRNA nucleotide sequence databases as references for the nucleotide sequences obtained from sequencing. According to the previous research (Prima et al., 2021), the amplification of the 16S rRNA gene utilizes a forward primer (specific to a given strain) designed based on a conserved region of the 16S rRNA gene that is genus-specific for bacteria. Table 5. Ability of Citrobacter freundii HT1 (HT1) and Proteus vulgaris HT3 (HT3) to improve cassava waste.
Table 6. Amino acids of fermented cassava waste.
The results of the 16S rRNA gene sequence analysis for isolate HT1 from cassava waste yielded contig data from forward and reverse DNA sequencing, which were then compared with DNA sequences available in the GenBank to determine the level of similarity using the BLAST (Basic Local Alignment Search Tool) program on the NCBI (National Center for Biotechnology Information) website. Based on the BLAST results, it was determined that isolate HT1 shares the highest similarity with C. freundii strain S519, exhibiting a percentage identity of 99.79% (Table 3). Meanwhile, isolate HT3 exhibited the highest similarity with P. vulgaris strain VBE35, with a percentage identity of 99.72% (Table 4). Percentage identity refers to the degree of similarity between the input and target DNA sequences. Microorganisms using the 16S rRNA gene are considered identical (or similar) at the species level if the percentage identity exceeds 97.5% and at the genus level if it exceeds 95% (Stackebrandt and Goebel, 1994). The phylogenetic analysisThe phylogenetic analysis (Fig. 5) of isolate HT1, conducted using MEGA11 software, revealed that isolate HT1 was most closely related to C. freundii strain S519. Meanwhile, isolate HT3 was more closely related to P. vulgaris strain VBE35, as shown in the phylogenetic tree (Fig. 6). The phylogenetic tree illustrates the evolutionary relationships between bacterial species, showing their proximity or distance (Darupamenang et al., 2022). In this study, the phylogenetic tree positions the isolates HT1 and HT3 outside the main branches, suggesting that they can be classified as novel bacterial strains. These bacteria were therefore named C. freundii HT1 and P. vulgaris HT3. C. freundii exhibits growth in media containing cyanide, possibly due to the presence of enzymes capable of degrading cyanide (Snihur et al., 2018), although the extent of cyanide reduction was not measured. The results of this study support previous findings that the bacterial isolate HT1, classified as C. freundii is not only able to grow on substrates containing cyanide and degrade the cyanide present in cassava waste by producing the enzyme β-glucosidase. In addition, the isolate C. freundii HT1 produces cellulase enzymes capable of degrading crude fiber. Proteus vulgaris, identified in this study, is a bacterium capable of producing both β-glucosidase and cellulase, enabling it to degrade HCN and the crude fiber present in cassava waste. Previous studies have not identified P. vulgaris as capable of degrading HCN and cellulose. The findings of this study provide evidence that P. vulgaris HT1 is a novel strain capable of degrading both HCN and cellulose in cassava waste. Crude fibers of fermented cassava wasteCrude fibers can be reduced by cellulolytic bacteria that exhibit high cellulase enzyme activity. These bacteria are commonly found in landfill sites containing cassava waste or within the cassava waste itself (Gimba et al., 2021; Triani et al., 2024). The crude fiber content in this fermentation treatment was significantly lower than the crude fiber content without fermentation (21.96% (Triani et al., 2024). Fermentation of cassava waste using C. freundii HT1 and P. vulgaris HT3, either as single inoculants or in combination, for 15 days resulted in a 57.92% reduction in crude fiber content. Meanwhile, after 5 and 10 days of fermentation, the crude fiber content decreased by 53.14% and 53.68%, respectively. Fermentation of cassava waste using C. freundii HT1 and P. vulgaris HT3 was the most effective method for reducing crude fiber. This is due to the production of cellulase and β-glucosidase enzymes by these bacteria, with the synergy of these two enzymes enhancing the degradation of cellulose. Cellulase is a potent enzyme capable of degrading the strong polymer structure of cellulose. Thus, the combination of several enzymes, including cellulase and β-glucosidase, is essential for effective cellulose degradation. The degradation of cellulose requires three distinct enzymes to convert the polymer substrate into monomeric glucose substrates: endoglucanase (endocellulase), exoglucanase (exocellulase), and β-glucosidase. These enzymes hydrolyze and break glycosidic bonds, playing different roles in cellulose hydrolysis. Endoglucanase releases cellooligosaccharides by degrading long polymer chains in cellulose, and exoglucanase cleaves the ends of these chains to release cellobiose, which is then hydrolyzed by β-glucosidase to release glucose (Machiel et al., 2023; Datta, 2024). HCN in fermented cassava wasteCassava waste without fermentation contains 155.82 ppm of HCN Triani et al., 2024. However, through the biotechnology of fermenting cassava waste using C. freundii HT1, cyanide levels can be reduced by 78.82% after 15 days of fermentation. Fermentation using Proteus vulgaris HT3 as an inoculant for 5 days reduced HCN by 79.85%. The combined inoculants of bacteria with a fermentation duration of 5 days reduced HCN by 80.02%. The results showed that as the fermentation duration of C. freundii HT1 increased, the cyanide content decreased. This is because a prolonged fermentation period leads to an increase in the bacterial population, resulting in the production of more β-glucosidase enzymes, which accelerate the HCN in cassava waste. Fermentation of cassava waste using P. vulgaris HT3 showed that cyanide levels significantly increased after 5 days of fermentation. This result was attributed to the longer fermentation duration, which led to the production of secondary metabolites, including HCN, by P. vulgaris HT3. This finding aligns with a previous study (Li et al., 2023), which explained that P. vulgaris can produce the aromatic cyanoglucoside amygdalin, which accumulates and is converted into HCN. When fermented using a combination of C. freundii HT1 and P. vulgaris HT3, cyanide levels remained lower during fermentation durations of 5 and 10 days. This suggests that the synergistic effect of the two bacteria is most effective for up to 10 days. A high concentration of β-glucosidase enzyme, produced by C. freundii HT1 and Proteus vulgaris HT3, can effectively reduce cyanide levels in cassava waste. The β-glucosidase enzyme is classified within the glycoside hydrolase family and plays a crucial role in the hydrolysis of cyanogenic glucosides (Sengupta et al., 2023). In this process, cyanogenic glucosides are hydrolyzed by β-glucosidase into β-D-glucopyranose and acetone cyanohydrin. The cyanohydrin is then converted into acetone and cyanide. Cyanide, with the assistance of enzymes such as cyanase, cyanide hydratase, and cyanide dehydratase, is further hydrolyzed into carbon dioxide (CO2), ammonia, and formic acid, as part of the metabolic processes supporting bacterial growth (Mislah et al., 2018; Zhang et al., 2024). Crude protein of fermented cassava wasteThe results of this study showed that the P. vulgaris HT3 inoculant, with 5 and 10 days of fermentation, produced higher crude protein levels compared with the combination inoculant (C. freundii HT1 + P. vulgaris HT3) with 10 and 15 days of fermentation, and fermentation by C. freundii HT1 alone for 15 days. This is because the growth rate of P. vulgaris HT3 is faster than that of C. freundii HT1, leading to a larger bacterial population, which enhances protein fermentation in cassava waste. Bacteria are single-celled organisms that can increase the protein content of feed ingredients. A high microbial population during fermentation boosts the protein content of the material through protein synthesis within the bacterial cells. Protein synthesis involves the formation of polypeptide compounds in bacterial cells, which are essential for bacterial reproduction. These compounds ultimately increase the protein content in the feed. Fermentation using microbes is a highly effective method for converting nonfood biomass into protein (Zhang et al., 2024). The results illustrated that cassava waste fermented with C. freundii HT1 for 10 and 15 days resulted in protein levels of 16.77% and 17.67%, respectively. These protein values were higher than the fermentation duration of 5 days. This was because the growth profile of C. freundii HT1 was slower, allowing the bacteria to remain in the growth phase, even at 15 days. The growth profile of bacteria is influenced by factors such as the bacterial type, available nutrients, and substrate on which they grow (Kumakura et al., 2023). The crude protein content of unfermented cassava waste (peel and leaves) is only 1.84% (Triani et al., 2024). However, fermentation with C. freundii HT1 and P. vulgaris HT3 increased the crude protein content of cassava waste from 25.90% to 56.08%. pH of fermented cassava waste The results showed that during fermentation using C. freundii HT1, the pH value at 5 and 10 days was significantly higher than that at 15 days. This was because the bacteria were still in the growth phase, meaning that the fermentation process had not yet been completed. When the fermentation duration was extended to 15 days, the pH of the fermented cassava waste significantly decreased due to the increased production of organic acids resulting from the growing bacterial population. Fermentation using P. vulgaris HT3 or a combination of inoculants showed that after 5 days, the pH value after 5 days compared to fermentation with C. freundii HT1 for the same period. This was because the growth profile of P. vulgaris was faster, thus allowing the fermentation process to be completed within 5 days, as indicated by the lower pH. Extending the fermentation duration to 10 and 15 days did not reduce the pH because the bacteria entered the death phase. pH reduction is influenced by various biological factors, including genomic, biochemical, cellular, population, and ecosystem levels (Lund et al., 2020; Sandi et al., 2023). According to the study findings, cassava waste fermented for 15 days with C. freundii HT1, 5 days with P. vulgaris HT3, and 10 days with a combination of C. freundii HT1 and P. vulgaris HT3 showed improved quality. However, the highest quality cassava waste for feed use was produced by the C. freundii HT1 isolate after 15 days of fermentation. This resulted in the lowest crude fiber content, along with low pH, reduced cyanide levels, and high crude protein content. Amino acid and nutrient content of fermented cassava wasteThe analysis of amino acid content revealed that the best cassava waste was fermented for 15 days using C. freundii HT1, as shown in Table 6. The fermentation process resulted in higher essential amino acid concentrations. The amino acids in fermented cassava waste included threonine, valine, isoleucine, leucine, and phenylalanine at concentrations of 0.82%, 0.78%, 0.36%, 1.32%, and 0.70%, respectively. These values were significantly higher than those found in unfermented cassava waste, which contained 0.14% threonine, 0.17% valine, 0.14% isoleucine, 0.22% leucine, and 0.15% phenylalanine (Oladimeji et al., 2022). Amino acid content is closely associated with feed quality, particularly essential amino acid content. This is significant because essential amino acids cannot be synthesized by livestock and must therefore be included in their diets, where they are crucial for growth (Church et al., 2020). Diets containing higher levels of essential amino acids, such as lysine and methionine, are linked to improved meat production (Wu et al., 2021) and egg production (Djulardi et al., 2024). Table 7. Nutritional Content of Cassava Fermented Cassava Waste.
The nutritional content of cassava waste is presented in Table 7. The quality of fermented cassava waste is higher than that of unfermented cassava waste, indicating that fermented cassava waste has the potential to serve as an alternative feed. Fermentation not only enhances nutritional quality but also improves taste and aroma, while increasing the bioavailability of the product. ConclusionIn cassava waste, two novel bacterial strains were identified that produce cellulase and β-glucosidase enzymes with strong capabilities to degrade cellulose and cyanide: C. freundii HT1 and P. vulgaris HT3. Fermentation using a 3% inoculum of C. freundii HT1 for 15 days significantly reduced cyanide toxicity and improved the quality of cassava waste, making it a safe livestock feed. This process resulted in a crude fiber content of 9.24%, HCN of 33.01 ppm, crude protein of 17.67%, and pH of 4.28. AcknowledgmentWe express our gratitude to the Directorate General of Higher Education, the Faculty of Animal Husbandry at Andalas University, and the Indonesian National Research and Innovation Agency (BRIN) for their support, collaboration, and contributions to this research. Conflict of interestThe authors declare no conflicts of interest related to this research. FundingThis Research was supported by the Indonesian Ministry of Education and Culture, General of Higher Education, Research and Technology (contract number 32/UN16.19/PT.01.03/PL/2024. Author’s contributionHera Dwi Triani contributed to the conduct of the experiments, Ahadiyah Yuniza, and Yetti Marlida contributed to the development of the concept. Husmaini and Wulansih Dwi Astuti contributed to data analysis, and Gusri Yanti contributed to manuscript writing. All authors have approved the final version of the manuscript. Data availabilityAll data were provided in the manuscript. ReferencesAbdul, K.J., Nurul, M.H., Abir, H., Adil, M., Nazmul, I.F., Mubarack, H. and Muhammad M.H. 2024. Isolation, identification, and potentiality of gut-derived probiotic bacteria from Heteropneustes fossilis, stinging catfish. J. Adv. Vet. Anim. Res. 11, 560–572. Anjani, K.N., Baharuddin, H. and Paulus, H.A. 2021. Analysis of cyanide contents in cassava leaves (Manihot esculenta Crantz) based on boiling duration with formation of hydrindantin complex by using UV-Vis spectrophotometry. Akademika Kimia. 10, 49–52. AOAC. Official Methods of Analysis. 15th ed. (2021). Washington, DC: Official Analytic Chemists. APHA Cyanide extraction procedure for solid and oils. 2021. The methods for evaluating solid waste physical/chemical methods, US Enviromental Protection Agency. 3rd ed. Washington, DC. Ardiansyah, K.F., Dwi, P.S., Suci, A.P., Asep, A., Euis, K., Andi and Abu, B.S. 2018. Isolation and identification of cellulose-degrading bacteria from the tukak sadai mangrove ecosystem in South Bangka. Perikanan Pantura J. 1, 9–16. Astuti, W.D., Widyastuti, Y., Ridwan, R. and Yetti, E. 2013. Quality of vegetable waste silages treated with various carbohydrate sources. Med. Pet. 3, 120–125. CADIS for Agricultural Data and Information Systems. 2024. Agricultural Economic Support Statistics for 2023: Secretariat General of the Indonesian Ministry of Agriculture, Ministry of Agriculture, Indonesia and location is Jakarta. Church, D.D., Hirsch, K.R., Park, S., Kim, I.Y., Gwin, J.A., and Pasiakos, S.M. 2020. Essential amino acids and protein synthesis: insights into maximizing the muscle and whole-body response to feeding. Nutr. 12, 3717. Cho, W. and Myong, S.C. 2020. Bacillus spores: a review of their properties and inactivation processing technologies. Food Sci. Biotechnol. 11, 1447–1461. Darupamenang, S.A., Kolondam B.J., Ai, N.S. and Tallei, T.E. 2022. Phylogenetic analysis of alocasia genus. J. Bios Logos. 12, 157–163. Datta, R. 2024. Enzymatic degradation of cellulose in soil: a review. Heliyon. 10, e24022. Djulardi, A., Triani, H.D. and Yuniza, A. 2024. Study of avocado seed and banana peel processing as corn element substitution in Japanese quail (Coturnix-Coturnix Japonica) ration. Int. J. Vet. Sci. 13, 42–50. Enoch, N., Frances, E.C., Johnson, O.O., Eziamaka, A.E.C. and Onyinye, M. 2022. Proximate analysis and mineral composition of the peels of three varieties of sweet cassava. Asian J. Micr. Biotech. 7, 35–4. Gimba, A.Y., Abubakar, I., Abdullahi, H. and Opeyemi, N.H. 2021. Isolation and optimization of the fermentation condition of cellulolytic microbial isolates from cassava wastewater. GSC Bio. Phar. Sci. 14, 011–017. Gundersen, E., Christiansen, A.H.C., Jorgensen, and Lübeck, M. 2022. Production of leaf protein concentrates from cassava: protein distribution and anti-nutritional factors in biorefining fractions. J. Cleaner Prod. 379, 134730. Hawashi, M., Tri, W. and Setiyo G. 2019. Solid-state fermentation of cassava products for degradation of anti-nutritional value and enrichment of nutritional Value. Intech Open Publisher, London, United Kingdom. pp: 1–18 Kumakura, D., Ryo, Y., Hara, A. and Nakaoka, S. 2023. Disentagling the growth curve of microbial culture. J. Theoretical Bio. 573, 1–9. Li, G.Q., Kang, W.N., Zhang, X.Q., Jin, L. and Fu, K.Y. 2023. Proteus vulgaris strain Ld01-originated mandelonitrile defends Leptinotarsa decemlineata larvae and adults against predation. Res. Square. 15, 1–15. Lund, P.A, Biase, D.D., Liran, O., Scheler, O. Mira, N.P. Cetecioglu, Z., Fernández, E.N., Cid, S.B., Hall, R., Sauer, M. and Byrne, C.O. 2020. Understanding how microorganisms respond to acidic pH is central to their control and successful exploitation. Front. Micr. 11, 556140. Marlida, Y., Salam, M.K., Harnentis, Jamsari, Huda, N., Noordin, W.N.M., Anggraini, L. and Ardani L.R. 2023. Metagenomic analysis and biodiversity of bacteria in traditional fermented fish or budu from West Sumatera, Indonesia. J. Adv. Vet. Anim. Res. 10, 801–808. Mislah, A., Suharti, S. and Wijayanti, I. 2018. Product characteristics and effectiveness of encapsulation of hydrocyanic acid (HCN) degrading bacteria. Feed Tech. Nut. J. 16, 21–26. Nwakoby, N.E., Ezeogo, J.I., Orji, M.U. and Ejimator, C.F. 2021. Isolation and identification of bacteria and fungi from cassava mill effluent in afikpo, ebonyi state Nigeria. South Asian J. Res. Micr. 10, 18–28. Oladimeji, S.O., Adeyemi, A.A., Mosuro, A.O., Adebayo, B.F., Etop, S.C., Adebiyi, F.G. and Ogunwole, O.A. 2022. Nutritional composition of cassava (Manihot esculenta crantz) peel products. Livestock Res. Rural Development. 34, 1–7. Olurontolo, O.D. 2018. Infuence of enzyme supplementation on rabbits fed rumen liquor with poultry waste fermentated cassava peels based diet. Anim. Res. Int. 15, 2950–2964. Pazla, R., Yanti, G., Jamarun, N., Zain, M., Triani, H.D., Putri, E.M. and Srifani, A. 2024. Identification of phytase producing bacteria from acidifying tithonia diversifolia: potential for ruminant feed development. Saudi J. Biol. Sci. 31, 104006. Prima, S., Heppy, P., Endang and Rusfidra. 2021. Isolation characterization and identification of molecular lactic acid is isolation from bilih fish (Mystacoleucuspadangenesis) Lake Singkarak potential as probiotic. Ann. Roman. Soc. Cell. Bio. 25(6), 8581–8596. Roldan, M.D., Alfonso, O.A., Lara, PS., Purificacion, C., Victor, M.L. and Conrado, M.V. 2021. Bioremediation of cyanide-containing wastes. Embo Rep. 22, 1–5. Sandi, S., Prataman, A.N.T., Sahara, E. and Nurdin, A.S. 2023. The effect of fermentation duration on pH, total acid and ammonia deposition in vegetable market waste juice as a feed. J. Ilmu Pet. Terapan. 6, 51–57. Sengupta, S., Maithili, D. and Supratim, D. 2023. Β-Glukosidase : structure, function and aplication for industry. Sci. Direct Chap. 5, 97–120. Snihur, H., Petrenki, S., Kot, T., Shevchenko, O. and Polischuk, V. 2018. Widespread viral disease endangering cereal crops in ukraine. Mikrobiolohinhnyo Zhurnal. 8, 103–116. Srisaikham, S., Suksombat, W. and Lounglawan, P. 2018. Fresh cassava peel in dairy cattle diet: effects on milk production, hygienic quality of raw milk and somatic cell counts. Songklanakarin J. Sci. Tech. 40, 977–984. Stackebrandt, E. and Goebel, B.M. 1994. Taxonomic note: a place for DNA-DNA reassociation and 16S rRNA sequence analysis in the present species definition in bacteriology. Int. J. Syst. Evo. Micr. 44, 846–849. Steel R.G.D. and Torrie J.H. 1993. Principles and procedures of statistics. Jakarta, Indonesia: Gramedia Pustaka Utama Jakarta. Suharti, S., Hafni, O., Asep, S., Myunggi, B. and Komang, G.W. 2021. Effects of cyanide-degrading bacteria inoculation on performance, rumen fermentation characteristics of sheep fed bitter cassava (Manihot esculenta crans) leaf meal. Ann. Agric. Sci. 66, 131–136. Triani, H.D., Marlida, Y., Yuniza A, Husmaini and Astuti, W.D. 2024. Isolation and characterization of cellulose- and cyanide-degrading bacteria from cassava waste as inoculants in feed fermentation. Int. J. Vet. Sci. 13, 384–390. Triani, H.D., Marlida, Y., Yuniza, A., Astuti, W.D and Husmaini. 2024. Isolation and screening of cellulolytic bacteria from landfill of cassava waste. IOP Conf. Series Earth Environ. Sci. 13(3), 1341. Wea, R.A., Ninu and Koten, B.B. 2020. Nutritional and antinutrient quality of fermented liquid feed made from tamarind seeds. J. Pet. Indonesia. 22, 133–140. Wu, Y., Tang, J., Cao, B., Zhang, Y., Chen, M., Xie, Z., Zhou and Hou, S. 2021. Effects of dietary L-methionine supplementation on the growth performance, carcass traits, and plasma parameters of starter pekin ducks at different dietary energy levels. Animals, 11, 144–151. Zhang, Z., Xiaoyi, C. and Le, G. 2024. New strategy for the biosynthesis of alternative feed protein: single-cell protein production from straw-basedbiomass. Bioenergy 16, 1–18. | ||
| How to Cite this Article |
| Pubmed Style Triani HD, Yuniza A, Marlida Y, Husmaini H, Astuti WD, Yanti G. A novel bacterial approach to cassava waste fermentation: Reducing cyanide toxicity and improving quality to ensure livestock feed safety. Open Vet. J.. 2025; 15(3): 1358-1369. doi:10.5455/OVJ.2025.v15.i3.27 Web Style Triani HD, Yuniza A, Marlida Y, Husmaini H, Astuti WD, Yanti G. A novel bacterial approach to cassava waste fermentation: Reducing cyanide toxicity and improving quality to ensure livestock feed safety. https://www.openveterinaryjournal.com/?mno=234156 [Access: January 24, 2026]. doi:10.5455/OVJ.2025.v15.i3.27 AMA (American Medical Association) Style Triani HD, Yuniza A, Marlida Y, Husmaini H, Astuti WD, Yanti G. A novel bacterial approach to cassava waste fermentation: Reducing cyanide toxicity and improving quality to ensure livestock feed safety. Open Vet. J.. 2025; 15(3): 1358-1369. doi:10.5455/OVJ.2025.v15.i3.27 Vancouver/ICMJE Style Triani HD, Yuniza A, Marlida Y, Husmaini H, Astuti WD, Yanti G. A novel bacterial approach to cassava waste fermentation: Reducing cyanide toxicity and improving quality to ensure livestock feed safety. Open Vet. J.. (2025), [cited January 24, 2026]; 15(3): 1358-1369. doi:10.5455/OVJ.2025.v15.i3.27 Harvard Style Triani, H. D., Yuniza, . A., Marlida, . Y., Husmaini, . H., Astuti, . W. D. & Yanti, . G. (2025) A novel bacterial approach to cassava waste fermentation: Reducing cyanide toxicity and improving quality to ensure livestock feed safety. Open Vet. J., 15 (3), 1358-1369. doi:10.5455/OVJ.2025.v15.i3.27 Turabian Style Triani, Hera Dwi, Ahadiyah Yuniza, Yetti Marlida, Husmaini Husmaini, Wulansih Dwi Astuti, and Gusri Yanti. 2025. A novel bacterial approach to cassava waste fermentation: Reducing cyanide toxicity and improving quality to ensure livestock feed safety. Open Veterinary Journal, 15 (3), 1358-1369. doi:10.5455/OVJ.2025.v15.i3.27 Chicago Style Triani, Hera Dwi, Ahadiyah Yuniza, Yetti Marlida, Husmaini Husmaini, Wulansih Dwi Astuti, and Gusri Yanti. "A novel bacterial approach to cassava waste fermentation: Reducing cyanide toxicity and improving quality to ensure livestock feed safety." Open Veterinary Journal 15 (2025), 1358-1369. doi:10.5455/OVJ.2025.v15.i3.27 MLA (The Modern Language Association) Style Triani, Hera Dwi, Ahadiyah Yuniza, Yetti Marlida, Husmaini Husmaini, Wulansih Dwi Astuti, and Gusri Yanti. "A novel bacterial approach to cassava waste fermentation: Reducing cyanide toxicity and improving quality to ensure livestock feed safety." Open Veterinary Journal 15.3 (2025), 1358-1369. Print. doi:10.5455/OVJ.2025.v15.i3.27 APA (American Psychological Association) Style Triani, H. D., Yuniza, . A., Marlida, . Y., Husmaini, . H., Astuti, . W. D. & Yanti, . G. (2025) A novel bacterial approach to cassava waste fermentation: Reducing cyanide toxicity and improving quality to ensure livestock feed safety. Open Veterinary Journal, 15 (3), 1358-1369. doi:10.5455/OVJ.2025.v15.i3.27 |